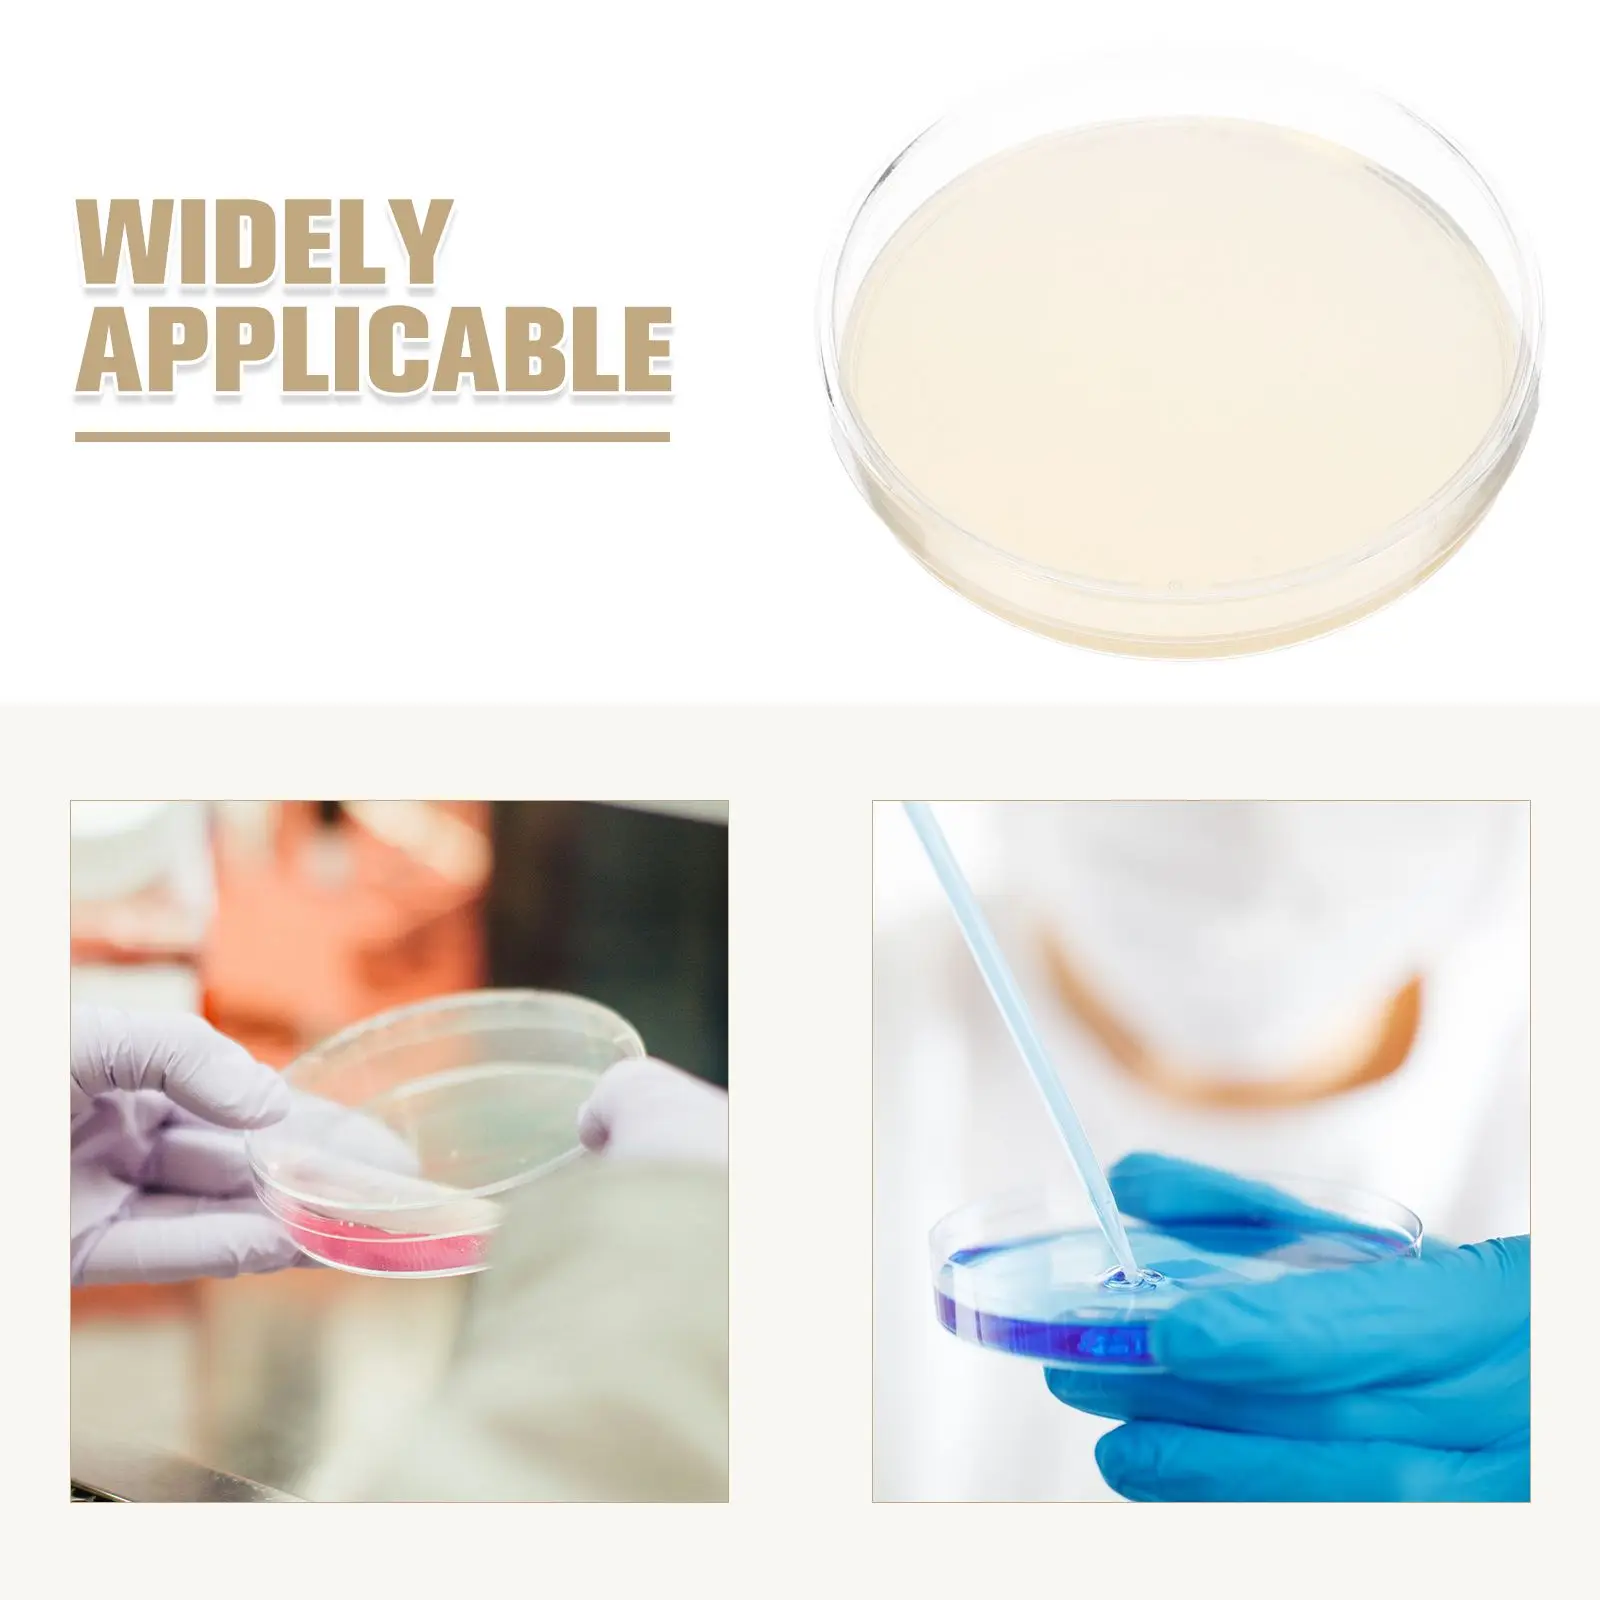
10 Pcs Agar Plates Laboratory Dishes Pre Poured Transparent Mycology Biological Equipment Medium Disposable Petri

9x10 см 100 шт. уплотнения собственной личности упаковывая мешок для Бизнес Кухня хранения печенья прозрачный карточки для леденцов подарок из...







sku: 1005002817191375
ACCORDING TO OUR RECORDS THIS PRODUCT IS NOT AVAILABLE NOW
$1.22
Shipping from: China
Customers also viewed

$9.66
For M 14 Angle Grinder Brazing Hole Electric Center Positioning Drill Adapter Center Drill With Angle Grinder For Hole Cutter
aliexpress.ru
$7.01
10 Pcs Agar Plates Laboratory Dishes Pre Poured Transparent Mycology Biological Equipment Medium Disposable Petri
aliexpress.ru
$21.08
AYUNSUE 2021 летнее женское пляжное платье с открытой спиной, женская одежда, Цветочное платье без рукавов, платья для женщин, повседневные платья
aliexpress.ru
$579.71
Niche Altar Guanyin God of Wealth Cabinet Chinese Style Buddha Cabinet Buddha Shrine Simple Tribute Table Incense Burner Table
aliexpress.ru
$2.91
NGK Spark Plugs Creative Personality Car Stickers Mug Guitar Laptop Camper Motorcycle Off-road Vehicle Skateboard Decals
aliexpress.ru
$14.20
Сумки для женщин, французская нишевая сумка на цепочке для женщин, новинка 2023, модная трендовая женская маленькая модная сумка-мессенджер через плечо
aliexpress.ru
$2.14
2 rolls of Violin Fretboard Stickers Violin Tapes Fingerboard Marking Violin Decals
aliexpress.ru
$16.19
5Pcs,Loudspeaker Bottom Loud Ringer Horn Flex Speaker For Xiaomi Mi 11 12 13 11T Lite Pro Ultra Buzzer Loud Speaker Flex Cable
aliexpress.ru
$82.88
Tesco Elegant Women's Coat Woolen Thickened Trench For Women Winter Wear Solid Slim Formal Outerwear For Office Wear Warm Jacket
aliexpress.ru
$9.85
Женское нижнее белье, латексный боди с открытой промежностью, бюстгальтер с открытой чашкой, облегающий костюм кошки, Блестящий Мокрый образ, эротическое нижнее белье на молнии
aliexpress.ru
$1.67
Electric Wire Stripping Plier Crimping Tool Auto Crimping Pliers Cutting Pressing Wire Stripper Self Adjusting Electrician Tool
aliexpress.com
$37.24
Автомобильный насос для шин, портативный мини-воздушный компрессор, ручной насос для шин для велосипедов и мотоциклов, автомобилей
aliexpress.ru
$235.20
High Quality Classic White Pearl Beaded Lace Mesh Embroidery Thread Sequins Fabric Wedding Dress Material for Women Evening Gown
aliexpress.com
$17.14
Women's Jeans Summer Fashion Solid Color Slim Tassel Stitching Jeans Women's Casual Mid Waist Button Denim Pencil Pants Trousers
aliexpress.com
$5.97
30mm42crmo seamless steel pipe precision pipe explosion-proof crack free lathe chamfering inner and outer mirror
aliexpress.com
$8.90
Адаптер питания переменного тока 19 в, 2,37 А, 45 Вт, зарядное устройство для ноутбука Acer Aspire, фотосессия
aliexpress.ru
$20.36
Veste Coupe-vent à Capuche Pour Homme, Manteau Chaud Et Doux, Parka Décontractée De Haute Qualité, Nouvelle Collection Printemps
aliexpress.com
$8.40
Colorful Acetate Fashion Round Eyewear Spectacle Frame Vintage Optical Female Beauty Lady Anti Blue Light Blocking Glasses UV400
aliexpress.com
$17.73
RFID Reader ID Chip Scanner Pet Certificate Handheld USB Dog Cat Animal Identification Tube Tag Card Reader Chip Transponder
aliexpress.com
$61.74
2022 самая популярная французская органза, уютная ткань, высокое качество, Африканский жаккард, Нигерия, кружева с вышивкой для свадебной веч...
aliexpress.ru
$19.23
Стеклянная бутылка для воды с натуральным хрустальным камнем, восстанавливающий камень, аметист, розовый кварц, чашка для питья, бутылка бе...
aliexpress.ru
$0.96
Fashion Simple Love Peach Heart Anklet Anklets For Women Ankle Bracelets For Women Accessories For Women Wholesale Jewelry Bling
aliexpress.com
$4.19
AnnmorsSilver Plated Zircon Zircon Edging Bracelet Charms Beads Elegant Fits Pandora Bracelets Charms Women Jewelry Light Blue
aliexpress.com
$6.57
Lukas, Одноразовый колпачок абразивный коричневый, мелкий абразив, 10шт (4 вида), 10 шт., 10 шт.
gracy.ru
$55.55
B75M-H DDR3 1155-Pin Computer Desktop Motherboard Kit Can Be Equipped with I3I5 3240 347
aliexpress.com
$12.32
Top. 1-4 Zigbee Temperature sensor SNZB-02 Humidity detector smart thermometer for home ewelink app control zbbridge required
aliexpress.com
$2.01
1 Pcs/lot 100% New SST28VF040A-200-4I-EH Original In Stock Bigger Discount for the More Quantity
aliexpress.com
$9.82
7 Colors For 2T-12Y Baby Girls Boys Sweatshirts For Spring Autumn Toddler Cotton Tops Fashion Sport Children Hoodies SweatShirt
aliexpress.com
$2.71
Щетка для бороды для мужчин, натуральная щетина кабана, ручка для подметания и смягчения усов, круглая расческа с деревянной ручкой, машинка...
aliexpress.com
$12.66
Articulated Slug Flexible Toy Fingertip Snail Fidget Toy Decompression Toy Kids Adult Stress Relief Sensory Antistress Toys Gift
aliexpress.com
$24.62
Suitable for SAMS UNG NOTE 7 / N935 NOTE FE mobile phone EB-BN935ABE built-in battery
aliexpress.com
$2.11
2022 теплая кровать для кошек, гамак для домашних животных, домик для отдыха и домашнего питомца, мягкая и удобная улыбка @ LS
aliexpress.com
$7.63
Pair Of Bicycle Pedal Cover Protective Cover Protective Case Outdoor Riding Pedal Protective Cover Mountain Bike Accessories
aliexpress.com
$11.49
6 шт., шестигранная акустическая панель, шестигранная Звукоизоляционная панель, для звукоизоляции и акустической обработки
aliexpress.ru
$4.67
12 шт. самодельные пустые браслеты Slap, сувениры вечерние, пасхальные подарки для детей, художественное ремесло
aliexpress.ru








